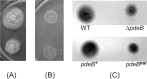

PdeB, a cyclic Di-GMP-specific phosphodiesterase that regulates Shewanella oneidensis MR-1 motility and biofilm formation
- PMID: 23794617
- PMCID: PMC3754596
- DOI: 10.1128/JB.00498-13
PdeB, a cyclic Di-GMP-specific phosphodiesterase that regulates Shewanella oneidensis MR-1 motility and biofilm formation
Abstract
Shewanella oneidensis MR-1, a gammaproteobacterium with respiratory versatility, forms biofilms on mineral surfaces through a process controlled by the cyclic dinucleotide messenger c-di-GMP. Cellular concentrations of c-di-GMP are maintained by proteins containing GGDEF and EAL domains, which encode diguanylate cyclases for c-di-GMP synthesis and phosphodiesterases for c-di-GMP hydrolysis, respectively. The S. oneidensis MR-1 genome encodes several GGDEF and EAL domain proteins (50 and 31, respectively), with a significant fraction (∼10) predicted to be multidomain (e.g., GGDEF-EAL) enzymes containing an additional Per-Arnt-Sim (PAS) sensor domain. However, the biochemical activities and physiological functions of these multidomain enzymes remain largely unknown. Here, we present genetic and biochemical analyses of a predicted PAS-GGDEF-EAL domain-containing protein, SO0437, here named PdeB. A pdeB deletion mutant exhibited decreased swimming motility and increased biofilm formation under rich growth medium conditions, which was consistent with an increase in intracellular c-di-GMP. A mutation inactivating the EAL domain also produced similar swimming and biofilm phenotypes, indicating that the increase in c-di-GMP was likely due to a loss in phosphodiesterase activity. Therefore, we also examined the enzymatic activity of purified PdeB and found that the protein exhibited phosphodiesterase activity via the EAL domain. No diguanylate cyclase activity was observed. In addition to the motility and biofilm phenotypes, transcriptional profiling by DNA microarray analysis of biofilms of pdeB (in-frame deletion and EAL) mutant cells revealed that expression of genes involved in sulfate uptake and assimilation were repressed. Addition of sulfate to the growth medium resulted in significantly less motile pdeB mutants. Together, these results indicate a link between c-di-GMP metabolism, S. oneidensis MR-1 biofilm development, and sulfate uptake/assimilation.
Figures

References
-
- Boehm A, Steiner S, Zaehringer F, Casanova A, Hamburger F, Ritz D, Keck W, Ackermann M, Schirmer T, Jenal U. 2009. Second messenger signalling governs Escherichia coli biofilm induction upon ribosomal stress. Mol. Microbiol. 72:1500–1516 - PubMed
-
- Cotter PA, Stibitz S. 2007. C-di-GMP-mediated regulation of virulence and biofilm formation. Curr. Opin. Microbiol. 10:17–23 - PubMed
-
- Dow JM, Fouhy Y, Lucey JF, Ryan RP. 2006. The HD-GYP domain, cyclic di-GMP signaling, and bacterial virulence to plants. Mol. Plant Microbe Interact. 19:1378–1384 - PubMed
-
- Jenal U. 2004. Cyclic di-guanosine-monophosphate comes of age: a novel secondary messenger involved in modulating cell surface structures in bacteria? Curr. Opin. Microbiol. 7:185–191 - PubMed
Publication types
MeSH terms
Substances
LinkOut - more resources
Full Text Sources
Other Literature Sources